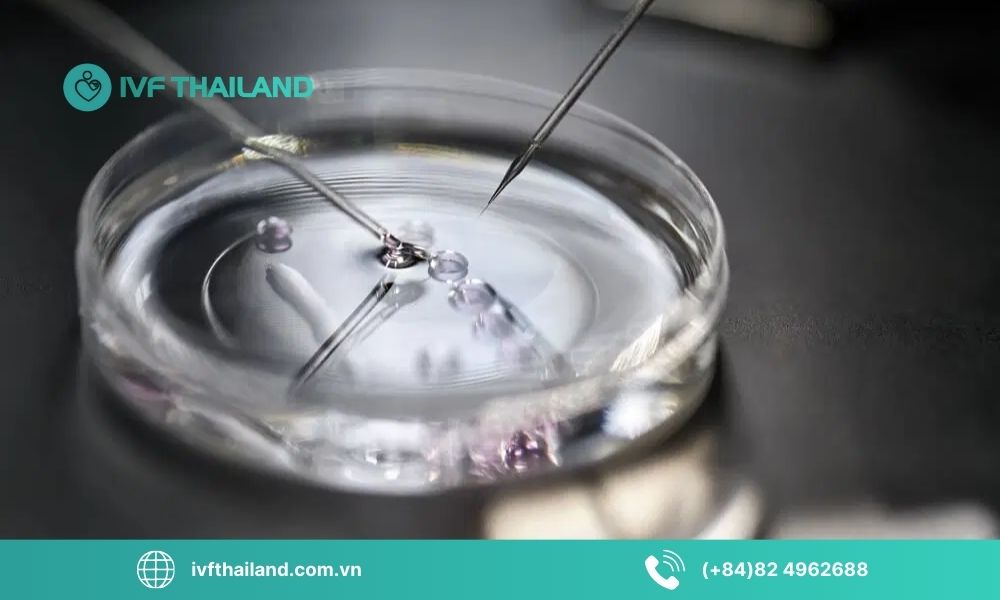
Khi nào nên áp dụng kỹ thuật PICSI?

PICSI là phương pháp chọn lọc tinh trùng dựa trên sinh lý, tập trung vào những tinh trùng khỏe mạnh, DNA ổn định, giúp tăng tỷ lệ phôi chất lượng trong IVF/ICSI. Cùng IVF ThaiLand tìm hiểu nguyên lý, ứng dụng và đối tượng phù hợp với kỹ thuật này qua bài viết dưới đây.
1. PICSI là gì?
Kỹ thuật PICSI (Physiological ICSI) là phương pháp chọn lọc tinh trùng dựa trên khả năng sinh lý, giúp nâng cao tỷ lệ thụ tinh thành công trong IVF/ICSI. Thay vì chỉ dựa vào hình thái học như ICSI truyền thống, PICSI tập trung vào những tinh trùng trưởng thành, có DNA ổn định và khả năng thụ tinh tốt nhất.
1.1 Khái niệm cơ bản về PICSI
PICSI là kỹ thuật lựa chọn tinh trùng dựa trên khả năng tương tác với Hyaluronan (HA), đây lầ một thành phần tự nhiên trong màng trứng. Tinh trùng trưởng thành, khỏe mạnh sẽ bám vào HA, trong khi tinh trùng chưa trưởng thành hoặc có DNA tổn thương sẽ không bám. Đây là cơ sở để các bác sĩ chọn lọc tinh trùng tốt nhất cho quá trình thụ tinh.
1.2 Nguyên lý hoạt động
Nguyên lý của PICSI dựa trên sự tương tác sinh lý giữa tinh trùng trưởng thành và Hyaluronan. Trong phòng thí nghiệm, tinh trùng được đặt trên đĩa chứa giọt HA. Chỉ những tinh trùng có khả năng bám HA mới được chọn để thực hiện ICSI. Cơ chế này đảm bảo rằng tinh trùng có cấu trúc DNA khỏe mạnh, giảm nguy cơ lỗi di truyền và tăng khả năng tạo phôi chất lượng cao.
1.3 Khác biệt giữa PICSI và ICSI thông thường
Khác với ICSI truyền thống, vốn chọn tinh trùng dựa trên hình thái học dưới kính hiển vi, PICSI dựa trên chức năng sinh lý thực sự của tinh trùng. Điều này giúp:
- Chọn được tinh trùng trưởng thành, DNA ổn định.
- Tăng tỷ lệ phôi chất lượng cao.
- Giảm nguy cơ sẩy thai và dị tật di truyền.
Kỹ thuật PICSI không chỉ giúp lựa chọn tinh trùng khỏe mạnh, DNA ổn định mà còn nâng cao tỷ lệ thụ tinh thành công và chất lượng phôi so với ICSI truyền thống, trở thành giải pháp tối ưu cho những gia đình muốn tăng cơ hội thụ tinh an toàn, hiệu quả.
PICSI là gì?
2. Ưu điểm nổi bật của kỹ thuật PICSI
Kỹ thuật PICSI giúp chọn lọc tinh trùng khỏe mạnh, trưởng thành và DNA ổn định, từ đó nâng cao tỷ lệ thụ tinh, tạo phôi chất lượng cao và giảm nguy cơ tổn thương di truyền. Dưới đây là những ưu điểm nổi bật của phương pháp này.
2.1 Loại bỏ tinh trùng non, bất thường hình thái
PICSI giúp loại bỏ những tinh trùng chưa trưởng thành hoặc có hình thái bất thường. Chỉ tinh trùng có khả năng bám vào Hyaluronan mới được chọn, đảm bảo tinh trùng sử dụng cho ICSI là tinh trùng trưởng thành, khỏe mạnh và phù hợp cho thụ tinh.
2.2 Giảm nguy cơ tổn thương ADN tinh trùng
Nhờ chọn lọc tinh trùng dựa trên chức năng sinh lý thực sự, PICSI giúp giảm nguy cơ tổn thương DNA tinh trùng. Điều này không chỉ nâng cao khả năng thụ tinh mà còn cải thiện chất lượng phôi, giảm nguy cơ dị tật di truyền cho thai nhi.
2.3 Tăng tỷ lệ thụ tinh, phát triển phôi chất lượng tốt
Tinh trùng trưởng thành, DNA ổn định giúp tăng tỷ lệ thụ tinh thành công và khả năng phát triển phôi chất lượng cao. Điều này đặc biệt quan trọng với những trường hợp IVF/ICSI khó, tăng cơ hội mang thai thành công cho các cặp vợ chồng.
2.4 Giảm nguy cơ sảy thai sớm
Sử dụng tinh trùng khỏe mạnh, trưởng thành và DNA ổn định giúp giảm nguy cơ sảy thai sớm, nâng cao tỷ lệ duy trì thai kỳ. Đây là một trong những ưu điểm nổi bật khiến PICSI trở thành lựa chọn ưu tiên trong thụ tinh nhân tạo.
Ưu điểm nổi bật của kỹ thuật PICSI
3. Khi nào nên áp dụng kỹ thuật PICSI?
Kỹ thuật PICSI không phải lúc nào cũng cần thiết cho mọi trường hợp IVF/ICSI. Việc lựa chọn áp dụng phương pháp này nên dựa trên tình trạng sức khỏe sinh sản và nhu cầu nâng cao tỷ lệ thành công. Dưới đây là những trường hợp nên cân nhắc sử dụng PICSI:
3.1 Cặp vợ chồng thất bại nhiều lần trong IVF hoặc ICSI
Những cặp vợ chồng đã trải qua nhiều chu kỳ IVF hoặc ICSI nhưng chưa thành công có thể hưởng lợi từ PICSI. Kỹ thuật này giúp lựa chọn tinh trùng khỏe mạnh hơn, tăng khả năng thụ tinh và phát triển phôi chất lượng cao, cải thiện tỷ lệ mang thai thành công.
3.2 Trường hợp sảy thai liên tiếp không rõ nguyên nhân
Với những phụ nữ có tiền sử sảy thai liên tiếp mà không tìm ra nguyên nhân, PICSI có thể giảm nguy cơ thất bại nhờ chọn lọc tinh trùng trưởng thành, DNA ổn định, từ đó hỗ trợ phôi phát triển khỏe mạnh và ổn định hơn.
3.3 Nam giới có tỷ lệ tinh trùng bất thường cao
Nam giới có tinh trùng bất thường về hình thái, di động kém hoặc DNA tổn thương cao sẽ được lợi từ PICSI. Phương pháp này giúp lọc ra tinh trùng khỏe mạnh, tăng khả năng thụ tinh và giảm nguy cơ dị tật di truyền.
3.4 Khi cần lựa chọn tinh trùng chất lượng tốt nhất cho phôi
Trong các trường hợp cần tối ưu hóa chất lượng phôi, PICSI giúp đảm bảo chỉ tinh trùng trưởng thành, khỏe mạnh được sử dụng, nâng cao tỷ lệ phôi chất lượng cao, từ đó tăng cơ hội thành công cho IVF/ICSI.
Khi nào nên áp dụng kỹ thuật PICSI?
4. Lưu ý và kinh nghiệm khi áp dụng PICSI
Kỹ thuật PICSI mang lại nhiều lợi ích nhưng cũng cần được áp dụng đúng đối tượng và dưới sự hướng dẫn chuyên môn. Dưới đây là những lưu ý và kinh nghiệm quan trọng để tối ưu hiệu quả khi sử dụng phương pháp này:
- Tham khảo ý kiến bác sĩ chuyên khoa: Trước khi quyết định áp dụng PICSI, các cặp vợ chồng nên tham khảo ý kiến bác sĩ chuyên khoa sinh sản để xác định phương pháp phù hợp với tình trạng sức khỏe và nhu cầu sinh sản.
- Lựa chọn trung tâm hỗ trợ sinh sản uy tín: Chọn cơ sở IVF/ICSI uy tín với phòng lab hiện đại, đội ngũ chuyên gia giàu kinh nghiệm sẽ đảm bảo quy trình PICSI được thực hiện chính xác, an toàn và hiệu quả.
- Kết hợp chế độ ăn uống và sinh hoạt lành mạnh: Chuẩn bị sức khỏe tổng thể, duy trì chế độ dinh dưỡng hợp lý, tránh căng thẳng và thói quen xấu giúp nâng cao chất lượng tinh trùng và trứng, tối ưu hiệu quả của PICSI.
- Chuẩn bị tài chính: Chi phí PICSI thường cao hơn ICSI truyền thống do yêu cầu kỹ thuật và trang thiết bị đặc biệt. Các cặp vợ chồng nên dự trù ngân sách phù hợp trước khi thực hiện.
Việc áp dụng PICSI hiệu quả phụ thuộc vào việc lựa chọn đúng đối tượng, trung tâm uy tín và chuẩn bị sức khỏe cùng tài chính hợp lý. Tuân thủ các lưu ý trên sẽ giúp tối ưu tỷ lệ thụ tinh, chất lượng phôi và tăng cơ hội mang thai thành công.
Lưu ý và kinh nghiệm khi áp dụng PICSI
5. IVF ThaiLand – Trung tâm hỗ trợ sinh sản uy tín hàng đầu tại Thái Lan
IVF ThaiLand là một trong những trung tâm hỗ trợ sinh sản uy tín hàng đầu tại Thái Lan, nổi bật với công nghệ hỗ trợ sinh sản hiện đại, phòng lab đạt chuẩn quốc tế và đội ngũ chuyên gia giàu kinh nghiệm
Chúng tôi cam kết:
- Cung cấp dịch vụ hỗ trợ sinh sản an toàn, chuẩn quốc tế.
- Sử dụng công nghệ IVF/ICSI và kỹ thuật PICSI hiện đại, nâng cao tỷ lệ thụ tinh thành công.
- Đội ngũ bác sĩ và chuyên gia giàu kinh nghiệm, tận tâm với từng trường hợp.
- Tư vấn cá nhân hóa, hỗ trợ chăm sóc trước, trong và sau quá trình điều trị.
- Minh bạch chi phí và thông tin, đảm bảo quyền lợi tối đa cho khách hàng.
Với cam kết về chất lượng, công nghệ hiện đại và đội ngũ chuyên gia giàu kinh nghiệm, IVF ThaiLand đảm bảo mang đến giải pháp sinh sản an toàn, hiệu quả và tối ưu hóa cơ hội mang thai thành công cho mọi cặp vợ chồng.
IVF ThaiLand – Trung tâm hỗ trợ sinh sản uy tín hàng đầu tại Thái Lan
Nếu bạn đang tìm kiếm giải pháp sinh sản an toàn và hiệu quả, IVF ThaiLand với công nghệ hiện đại và đội ngũ chuyên gia giàu kinh nghiệm sẽ đồng hành, tư vấn và hỗ trợ toàn diện để tối ưu cơ hội mang thai thành công cho gia đình bạn. Liên hệ ngay với IVF ThaiLand để được tư vấn chi tiết và bắt đầu hành trình sinh sản hiệu quả.
THÔNG TIN LIÊN HỆ
IVF THAILAND
Hotline Vietnam: (+84)82 4962688
Hotline Thailand: (+66)924 979 928
Email: daisyvu6565@gmail.com
Website: ivfthailand.com.vn
Fanpage: IVF Thailand – TTON Tại Thái Lan & IVF tại Thái Lan